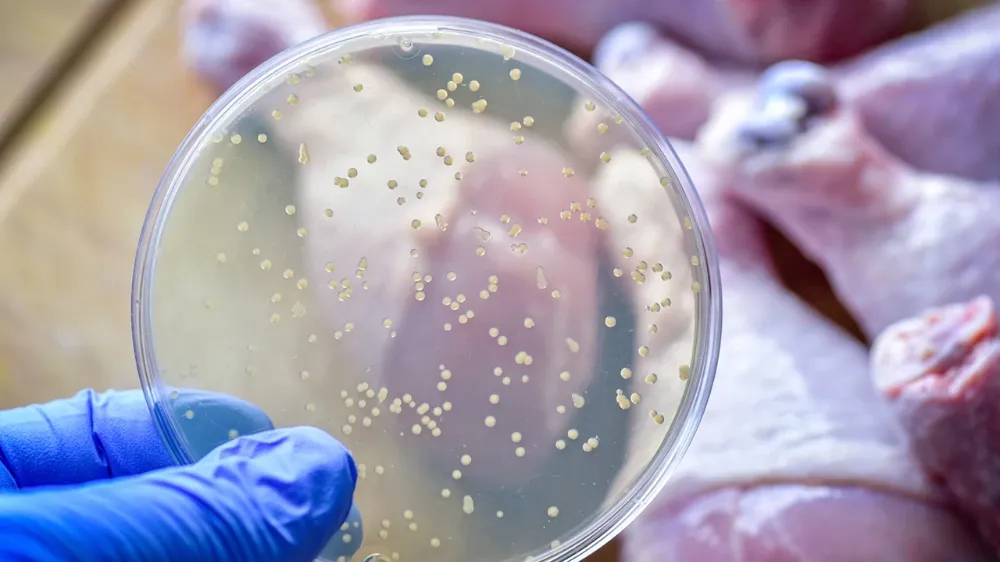

Gıda kaynaklı hastalıkların başında gelen ve her yıl milyonlarca kişiyi etkileyen Salmonella enfeksiyonlarına karşı uluslararası bilim topluluğu kritik bir eylem çağrısında bulundu.
Yaz aylarında artış gösteren ve yüksek risk gruplarında (çocuklar, yaşlılar ve bağışıklığı zayıf kişiler) ölümcül sonuçlara yol açabilen bu bakteriye karşı korunmanın en temel ve kanıtlanmış yolları, dünyanın önde gelen gıda güvenliği uzmanları tarafından net bir dille kamuoyuna iletildi.
BİLİMSEL ARAŞTIRMALAR IŞIĞINDA DÖRT TEMEL ADIM
ABD Hastalık Kontrol ve Korunma Merkezleri (CDC) verilerine göre, Salmonella her yıl ABD’de yaklaşık milyon enfeksiyona, hastaneye yatışa ve ölüme neden oldu. Bu çarpıcı istatistikler ışığında, uzmanlar korunma çabalarının odaklanması gereken "Altın Kurallar"ı dört ana başlıkta topladı:
1. Ayır: Çapraz Bulaşmayı Önle
Gıda güvenliği konusunda dünyanın en saygın otoritelerinden, Londra Hijyen ve Tropikal Tıp Okulu'ndan (LSHTM) Prof. Dr. Sarah O’Brien, çiğ et ve tavuk gibi ürünlerin sebze, salata ve pişmeye hazır diğer yiyeceklerle temas etmesinin en büyük risk faktörü olduğunu ifade etti.
Prof. O’Brien, yaptığı açıklamada, "Çapraz bulaşma, Salmonella’nın mutfak içinde yayılmasının birincil yoludur. Kesme tahtaları, bıçaklar ve tezgah yüzeyleri farklı gıda türleri için kesinlikle ayrılmalıdır. Bir araştırmamız, çiğ etin kesildiği tahtanın doğru temizlenmemesi durumunda, takip eden gıdaya fazla bakteri transfer edebildiğini gösterdi" dedi.
2. Temizle: Doğru ve Yeterli Hijyen Şart
Teksas A&M Üniversitesi'nden Gıda Bilimi ve Teknolojisi Bölümü Başkanı Dr. Christopher R. Taylor, ellerin yıkanmasının önemini vurgularken, yüzeylerin de göz ardı edilmemesi gerektiğini belirtti.
Dr. Taylor, "Salmonella, kurutulmuş yüzeylerde bile uzun süre hayatta kalabilen dirençli bir bakteridir. Dünya Sağlık Örgütü (DSÖ) tarafından desteklenen çalışmalar, ellerin en az saniye boyunca sabunla yıkanmasını şart koştu. Pişirme öncesinde, sırasında ve sonrasında ellerin yıkanmaması, gıda zincirine doğrudan bakteri girişi anlamına gelir" diye konuştu.
3. Pişir: Isı, Bakteriye Karşı En Güçlü Silah
Salmonella’yı tamamen yok etmenin en etkili yolunun yeterli ısı uygulaması olduğu bilimsel olarak kanıtlandı.
Gıda Bulaşan Hastalıklar ve Önleme Enstitüsü'nden (IFSH) Dr. Maria Sanchez, özellikle kümes hayvanları ve kıyma gibi yüksek riskli gıdaların iç sıcaklıklarının kritik seviyelere ulaştırılması gerektiğini belirtti.
Dr. Sanchez, "Tavuk etinin minimum iç sıcaklığının ulaşması, Salmonella dahil tüm vejetatif bakterileri etkili bir şekilde inaktive ettiğini biliyoruz. Termometre kullanmak, tahmin etmenin ötesinde hayati bir adımdır" ifadesini kullandı.
4. Soğut: "Tehlike Bölgesi"nden Uzak Tut
Uzmanlar, pişmiş yiyeceklerin hızlıca soğutulmasının, bakterilerin çoğalmasını engellemede en kritik adımlardan biri olduğunu belirtti.
Küresel bilim topluluğu, bu dört "Altın Kural"ın, halk sağlığını koruma ve gıda güvenliği standartlarını yükseltme yolunda atılacak en temel adımlar olduğunun altını çizdi.
Haber: Mehmet Köpüklü / Haber Merkezi